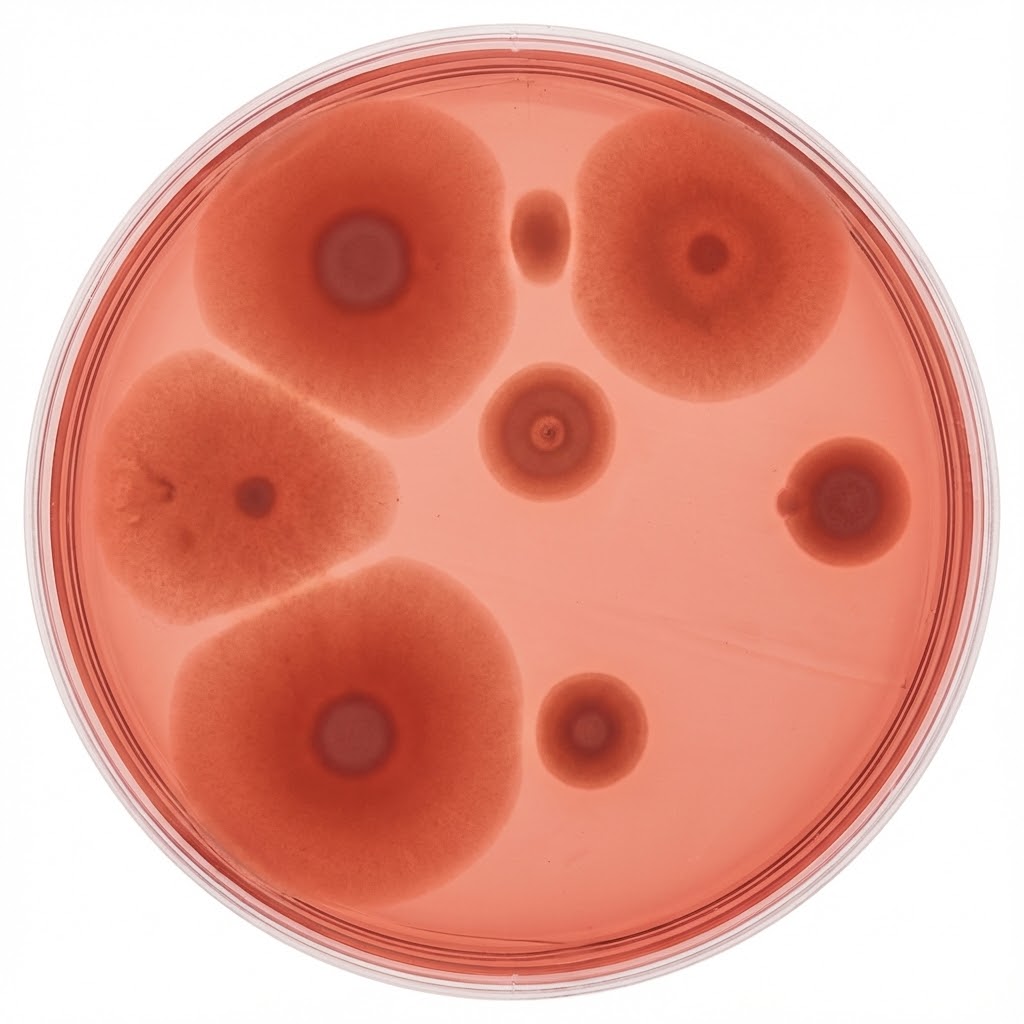
Prolin symboliseret ved en petriskål med rødbrune celler.

Prolin og kræft
Resumé om Prolin
Virkning:
- Prolin er en aminosyre, der fungerer som en fundamental byggesten for kroppens bindevæv og kollagen. Den spiller en central rolle i at opretholde strukturel integritet i væv, sener og blodkar, hvilket er afgørende for heling og fysisk stabilitet.
Potentiale ved kræft:
- Det primære potentiale ligger i teorien om at styrke det bindevævet omkring en tumor. Ved at gøre vævet mere modstandsdygtigt, er målet at gøre det vanskeligere for kræftceller at nedbryde barrieren og sprede sig til andre dele af kroppen.
Vigtigste begrænsning:
- Visse kræftformer kan ændre deres stofskifte til at udnytte prolin som energikilde, hvorfor anvendelse altid bør ske i samråd med en behandler og ofte i kombination med andre stoffer som lysin og C-vitamin.
Hvad er Prolin

Prolin, ofte benævnt L-Prolin, er en såkaldt ikke-essentiel aminosyre. At den er ikke-essentiel betyder, at kroppen selv er i stand til at danne den, primært ud fra en anden aminosyre kaldet glutamat. Selvom kroppen selv producerer den, kan behovet i visse situationer – eksempelvis under alvorlig sygdom, stress eller ved heling af store sår – overstige kroppens egenproduktion. I disse tilfælde betragtes den som betinget essentiel.
Rent kemisk skiller prolin sig ud fra andre aminosyrer ved sin unikke cykliske struktur, hvilket gør den usædvanlig stiv. Denne stivhed er netop det, der giver kollagen – kroppens primære strukturprotein – sin styrke og stabilitet. Uden tilstrækkeligt prolin ville kroppens bindevæv, hud, sener og blodkarvægge miste deres strukturelle integritet [1].
Historie
Prolin blev først isoleret i 1901 af den tyske kemiker Hermann Emil Fischer fra kasein (mælkeprotein). Gennem det 20. århundrede blev dets rolle som den primære komponent i gelatine og kollagen fastslået. I komplementær medicin har prolin historisk været anvendt til at støtte led, hud og hjerte-kar-systemet, og i nyere tid er interessen øget omkring dets rolle i at styrke kroppens fysiske barrierer mod sygdomsinvasion.
Virkningsmekanismer

Kroppens lim og stillads
Prolins absolut vigtigste opgave er at fungere som byggesten for kollagen. Kollagen er det protein, vi har mest af i kroppen, og det udgør cirka 30% af vores samlede proteinmasse. Man kan tænke på det som den “lim” eller det stillads, der holder sammen på alt fra hud og knogler til blodkar og organer. Uden tilstrækkeligt prolin mister dette stillads sin bæreevne.
Samspillet med C-vitamin
Når prolin skal indbygges i kollagen, gennemgår det en forvandling til hydroxyprolin. Denne proces kan kun lade sig gøre, hvis der er C-vitamin til stede. Det er netop denne omdannelse, der gør kollagenfibrene i stand til at binde sig stærkt sammen på kryds og tværs. Det sikrer en stabil og elastisk struktur, så vores blodkar eksempelvis kan give sig uden at briste, og huden holder sig fast.
Beskyttelse mod stress i cellerne
Helt nede på celleniveau har prolin også en beskyttende funktion. Det hjælper cellerne med at styre balancen af væske og salte (osmose), især hvis kroppen er presset eller stresset. Samtidig fungerer prolin som et signalstof, der er med til at styre, hvordan cellen omsætter energi og overlever i pressede situationer.
Det vigtige makkerpar
Når det handler om at holde vævet stærkt, arbejder prolin tæt sammen med aminosyren lysin. Man kan sige, at mens prolin sørger for selve stabiliteten og opbygningen, så hjælper lysin med at bremse nedbrydningen af kollagenet. De to supplerer altså hinanden i at bevare vævets styrke [2].
Potentiale ved kræft

Det onkologiske potentiale ved prolin adskiller sig markant fra stoffer, der søger at dræbe kræftceller direkte (cytotoksisk effekt).
En strategi om inddæmning
Tilgangen med prolin adskiller sig markant fra kemoterapi og stråling, der har til formål at slå kræftcellerne direkte ihjel (cytotoksisk effekt). Ved anvendelse af Prolin er fokus i stedet på at styrke kroppens egne forsvarsværker, så kræften får sværere ved at vokse ind i rask væv.
De biologiske sakse
Kræftceller har en unik evne til at udskille enzymer, kendt som matrix metalloproteinaser (MMP’er), der fungerer som en “biologisk saks”. Disse enzymer nedbryder det omkringliggende bindevæv (den ekstracellulære matrix), hvilket gør det muligt for kræftcellerne at bevæge sig frit, invadere nærliggende væv og til sidst sprede sig via blod- eller lymfebaner (metastasering).
Styrkelse af muren
Teorien bag anvendelsen af prolin i denne sammenhæng er, at ved at tilføre rigelige mængder af kollagenets byggesten – særligt i kombination med lysin og C-vitamin – kan man styrke bindevævet så markant, at de enzymatiske sakse får svært ved at klippe sig igennem. Man forsøger så at sige at gøre “murene” omkring tumoren tykkere og stærkere. Hvis bindevævet er modstandsdygtigt nok, kan det potentielt indkapsle tumoren og forhindre dens udvidelse og spredning.
Et fjendtligt miljø for spredning
Hvis bindevævet omkring en tumor er stærkt og intakt, kan det potentielt indkapsle tumoren. Det forhindrer ikke nødvendigvis selve tumoren i at eksistere, men det begrænser dens farligste egenskab: evnen til at sprede sig. Studier har vist, at denne kombination af næringsstoffer kan hæmme kræftcellers evne til invasion in vitro (i reagensglas) og i dyremodeller.
Det handler altså om at ændre miljøet omkring kræftcellen, så det bliver fjendtligt over for spredning, frem for kun at angribe selve cellen. Dette koncept er særligt relevant, da spredning af kræft ofte er den mest kritiske faktor for sygdommens udfald [3].
Fordele ved Prolin

En væsentlig fordel ved prolin er dets evne til at fremme sårheling og genopbygning af væv. For mennesker, der gennemgår kirurgi i forbindelse med et kræftforløb, kan optimeret kollagendannelse være afgørende for, hvor hurtigt og pænt operationssår heler.
Derudover styrker prolin hjerte-kar-systemet ved at sikre, at arterievæggene forbliver fleksible og stærke, hvilket er generelt gavnligt for helbredet. Det er et naturligt forekommende stof i kroppen, hvilket betyder, at det generelt tolereres godt uden de voldsomme bivirkninger, man ofte ser ved syntetiske lægemidler. Prolin understøtter også led og brusk, hvilket kan være en fordel, hvis man oplever ledrelaterede bivirkninger fra anden behandling.
Prolin understøtter også led og brusk. Endvidere fungerer aminosyren som en modulator i centralnervesystemet, hvilket for nogle kan resultere i en mere rolig fysiologisk tilstand og forbedret søvnkvalitet. Denne effekt synes at være mest udtalt, når prolin indtages i kombination med andre støttende næringsstoffer som magnesium og lysin.
Ulemper og begrænsninger

Det er vigtigt at forstå, at prolin-metabolismen er kompleks. Forskning har vist, at visse kræfttyper under hypoxi (iltmangel) eller stress kan opregulere et enzym kaldet PRODH (prolin dehydrogenase). Dette enzym kan nedbryde prolin for at generere energi (ATP) og reaktive iltforbindelser, som i værste fald kan fremme kræftcellens overlevelse under barske forhold. [5]
Derfor er prolin ikke en “one-size-fits-all” løsning. Hvis en specifik tumor er afhængig af prolin-metabolisme for at vokse, kan et isoleret tilskud teoretisk være kontraproduktivt.
Det understreger betydningen af, at prolin sjældent bør stå alene, men indgå i en protokol (ofte med lysin, C-vitamin og EGCG fra grøn te), der samlet set hæmmer kræftvækst, frem for blot at levere brændstof. Det kræver kyndig vejledning at navigere i denne balance.
Hvilke kræftformer er der tale om
Når forskningen [4, 5] beskriver kræftcellers evne til at udnytte prolin som brændstof via enzymet PRODH – især når de er pressede af iltmangel – peger pilen oftest på disse specifikke kræftformer:
- Brystkræft (især metastatisk): Forskning har vist, at visse aggressive brystkræftceller har et højt niveau af PRODH. De bruger prolin-nedbrydning til at skabe energi (ATP), hvilket hjælper dem med at overleve, når de river sig løs og skal danne metastaser andre steder i kroppen (lunger/ knogler).
- Lungekræft (ikke-småcellet, NSCLC): Her har man set, at prolin-metabolisme kan spille en rolle for kræftcellernes vækst og overlevelse.
- Bugspytkirtelkræft (pancreas cancer): Disse tumorer vokser ofte i et miljø med meget lidt ilt og næring (et “fattigt” miljø). For at overleve dette “sult-miljø” er de mestre i at finde alternative energikilder, herunder prolin, som de henter ved at nedbryde det omkringliggende væv.
- Prostatakræft: Også her er der observeret ændringer i prolin-metabolismen, som cellerne kan udnytte til vækst.
Det vigtige nuance
Det er dog uhyre komplekst. I nogle stadier af sygdommen fungerer PRODH faktisk som en tumor-hæmmer (ved at stresse cellen til døde med frie radikaler), mens det i andre stadier (især de sene/ aggressive under iltmangel) fungerer som overlevelsesmekanisme.
Derfor er konklusionen vigtig
Det er netop på grund af denne risiko ved de nævnte kræfttyper, at man i komplementær onkologi (f.eks. Dr. Raths protokol) aldrig anbefaler Prolin som et “stand-alone” produkt (alene).
Når det gives sammen med Lysin, C-vitamin og EGCG (Grøn te), ændres billedet. EGCG og Lysin arbejder på at lukke/ hæmme kræftcellens pathways, så den ikke kan udnytte energien, mens Prolinen går til at styrke bindevævet (muren) i stedet for at fodre cellen.
Kliniske studier

Forskningen i prolin som enkeltstående kræftbehandling hos mennesker er begrænset. De mest overbevisende resultater stammer fra studier, hvor prolin er en del af en synergetisk blanding.
Et in vivo studie (i levende organismer) undersøgte effekten af en næringsstofblanding bestående af lysin, prolin, arginin, ascorbinsyre (C-vitamin) og grøn te-ekstrakt på humant osteosarkom (knoglekræft) indsat i mus. Resultaterne viste en signifikant hæmning af tumorvækst og nedsat MMP-udskillelse, hvilket støtter teorien om bindevævsstyrkelse.
Lignende resultater er set i in vitro studier (i reagensglas) på tværs af forskellige cellelinjer, herunder bryst-, lunge- og tyktarmskræft, hvor kombinationen af aminosyrer drastisk reducerede kræftcellernes evne til at invadere gennem en kunstig membran (matrigel). Det indikerer, at effekten er bredspektret over for spredningsmekanismen snarere end specifik for én kræfttype [4].
Sikkerhed
Prolin betragtes generelt som sikkert, da det er en aminosyre, vi naturligt indtager gennem kosten (kød, mejeriprodukter, æg). Der er ingen kendte alvorlige toksiske effekter ved normale doser.
Personer med svære nyre- eller leverlidelser bør dog være forsigtige med høje indtag af aminosyrer generelt, da det øger belastningen på disse organer i forhold til udskillelse af kvælstofaffald. Interaktioner med konventionel medicin er sjældne, men man bør altid informere sin behandler om alle tilskud.
Dispensering og anvendelse

Dosering af prolin sker ofte som en del af en bredere protokol for bindevævsstøtte. En typisk tilgang kan se således ud:
- Form: Kapsler eller pulver (L-Prolin).
- Kombination: Tages næsten altid sammen med L-Lysin og C-vitamin for at sikre korrekt kollagendannelse.
- Timing: Indtages gerne uden for måltider for at undgå konkurrence med andre aminosyrer fra kosten om optagelsen.
- Dosis: Doser varierer, men i terapeutiske sammenhænge ses ofte doser på mellem 500 mg og 2000 mg dagligt, fordelt over dagen.
- Opstart: Start langsomt op for at se, hvordan maven reagerer.
Eventuelt ubehag
- Kan hos enkelte give kvalme eller mavekneb, især ved indtagelse på tom mave. Hvis dette sker, kan man forsøge at trappe langsommere op, fordele dosis over flere gange eller indtage det sammen med en lille smule mad.
Konklusion

Prolin repræsenterer en interessant, understøttende tilgang til kræftbehandling, der fokuserer på at styrke kroppens eget forsvar – specifikt bindevævet – frem for blot at angribe tumoren. Ved at sikre byggestenene til en stærk kollagenstruktur, er målet at begrænse kræftens spredningsveje.
Selvom man skal være opmærksom på de metaboliske nuancer ved visse tumortyper, udgør prolin sammen med lysin og C-vitamin en lovende strategi for at fremme fysisk modstandskraft og dermed hæmme invasion (metastaser).
Tilbage til Kosttilskud
Se også Dr. Raths Protokol
Se også Bill Henderson Protokol
Links
[1] Proline Metabolism in Tumor Growth and Metastatic Progression (Frontiers in Oncology, 2020)
- Indhold: En videnskabelig gennemgang, der beskriver, hvordan prolin-tilgængelighed påvirker kollagensyntese og kræftcellers evne til at ændre form og sprede sig (plasticitet).
[2] The regulatory mechanisms of proline and hydroxyproline metabolism (Frontiers in Oncology, 2023)
- Indhold: En nyere artikel, der dykker ned i de mekanismer, der styrer dannelsen af prolin og kollagen, og hvordan disse processer er opreguleret i kræftvæv.
[3] Targeting extracellular matrix through phytochemicals (Frontiers in Pharmacology, 2023)
- Indhold: Beskriver strategien om at målrette behandlingen mod det omgivende væv (ECM) ved hjælp af naturlige stoffer for at forhindre kræftens spredning.
[4] Can proline dehydrogenase—a key enzyme involved in proline metabolism—be a novel target for cancer therapy? (Frontiers in Oncology, 2023)
- Indhold: Diskuterer prolin-metabolismens dobbelte rolle, og hvordan enzymet PRODH kan påvirke kræftudvikling, hvilket er relevant for afsnittet om ulemper.
[5] Proline Metabolism in Cancer: Emerging Roles in Redox Homeostasis (MDPI, Cancers, 2025)
- Indhold: Den absolut nyeste viden, der sammenfatter prolins betydning for kræftcellers energistofskifte og stressrespons, hvilket giver et helt opdateret billede af forskningen.
Siden er oprettet:
d. 31.12.25. Senest revideret d. 03.05.26
❤
Hvad du læser på Jeg har Kræft er ikke en anbefaling. Søg kompetent vejledning.
Forfatterinfo og professionelt grundlag

Samtlige artikler på dette site er udarbejdet og valideret af undertegnede, Hanne Kjær Uhlig. Jeg er uddannet sygeplejerske (1975, med klinisk erfaring frem til 2013) og cand.arch. (1983, med speciale i industriel design), samt underviser i en årrække på DTU (Danmarks Tekniske Universitet).
Efter tabet af min mor til kræft i 2000 og min egen kræftdiagnose i 2024, stiftede jeg dette non-profit informationssite Jeg har Kræft.
Målet er at bruge min analytiske og akademiske systematik til at bringe overblik, sikkerhed og videnskabelig dokumentation ind i feltet for integrativ, komplementær og alternativ kræftbehandling. Samtidig benyttes min sundhedsfaglige erfaring til at gøre artikler patientnære – og vedkommende.
Artiklens kendetegn:
- Klinisk og personlig ballast: Skabt ud fra en kombination af årtiers erfaring som sygeplejerske og egne oplevelser som patient og pårørende.
- Videnskabelig systematik: Indholdet bygger på systematisk research af medicinske databaser samt kliniske forsøg. Artiklerne er konsekvent underbygget med kildehenvisninger under Links.
- Uafhængigt non-profit projekt: Driften sikres via frivillige bidrag og medlemskaber gennem Støtteforeningen Jeg har Kræft. Sitet er fuldstændig uafhængigt af kommercielle producentinteresser og arbejder udelukkende for at fremme kræftramtes livskvalitet.
- Støtteforeningens bestyrelse består af:
- Formand: Hanne Kjær Uhlig , sygeplejerske og cand.arch.
- Kasserer: Jens Ottosen-Støtt, jurist
- Medlem: Thomas Kjær Uhlig, speciallæge, øjensygdomme
- Medlem: Martin Kjær Uhlig, cand.merc.aud.
Fællesskab: Bliv medlem af Facebookgruppen: Jeg har Kræft – Hvad kan jeg gøre?
❤
Hvad du læser på Jeg har Kræft er ikke en anbefaling. Søg kompetent vejledning.

